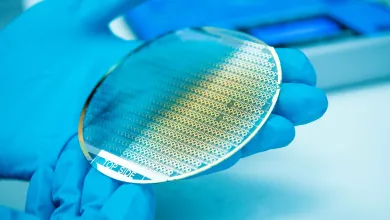
Pair of gloved hands holding a silicon disc chip

Skip to main content
-
Study
-
Student life
-
Research
-
Our impact
-
Research projects
-
Research areas
-
Research facilities
-
Collaborate with us
-
Institutes, centres and groups
-
Active Living
-
Advanced Fibre Applications
-
Advanced Laser Laboratory
-
Advanced Project Management Research Centre
-
Antibody and Vaccine Group
-
Astronomy Group
-
Autism Community Research Network @ Southampton (ACoRNS)
-
Bioarchaeology and Osteoarchaeology at Southampton (BOS)
-
Bladder and Bowel Management
-
Cell and Developmental Biology
-
Centre for Defence and Security Research
-
Centre for Developmental Origins of Health and Disease
-
Centre for Digital Finance
-
Centre for Eastern European and Eurasian Studies (CEEES)
-
Centre for Empirical Research in Finance and Banking (CERFIB)
-
Centre for Geometry, Topology, and Applications
-
Centre for Global Health and Policy (GHaP)
-
Centre for Green Maritime Innovation (cGMI)
-
Centre for Health Technologies
-
Centre for Healthcare Analytics
-
Centre for Human Development, Stem Cells and Regeneration
-
Centre for Imperial and Postcolonial Studies
-
Centre for Inclusive and Sustainable Entrepreneurship and Innovation (CISEI)
-
Centre for International Film Research (CIFR)
-
Centre for International Law and Globalisation
-
Centre for Internet of Things and Pervasive Systems
-
Centre for Justice Studies
-
Centre for Linguistics, Language Education and Acquisition Research
-
Centre for Machine Intelligence
-
Centre for Maritime Archaeology
-
Centre for Medieval and Renaissance Culture (CMRC)
-
Centre for Political Ethnography (CPE)
-
Centre for Research in Accounting, Accountability and Governance
-
Centre for Research on Work and Organisations
-
Centre for Resilient Socio-Technical Systems
-
Centre for Transnational Studies
-
Child and Adolescent Research Group
-
Clinical Ethics, Law and Society (CELS)
-
Clinical Legal Education
-
Computational Nonlinear Optics
-
Cyber Security Academy
-
Digital Oceans
-
EPSRC and MOD Centre for Doctoral Training in Complex Integrated Systems for Defence and Security
-
Economic Theory and Experimental Economics
-
Economy, Society and Governance
-
Electrical Power Engineering
-
Environmental Hydraulics
-
Gas Photonics in Hollow Core Fibres
-
Geochemistry
-
Global Health (Demography)
-
Global Health Community of Practice
-
Gravity group
-
High Power Fibre Lasers
-
Hollow Core Fibre
-
Human Genetics and Genomic Medicine
-
Infection
-
Infrastructure Group
-
Institute of Developmental Sciences
-
Institute of Maritime Law (IML)
-
Integrated Photonic Devices
-
Interdisciplinary Musculoskeletal Health
-
International Centre for Ecohydraulics Research (ICER)
-
Language Assessment and Testing Unit (LATU)
-
Laser-Direct-Write (LDW) Technologies for Biomedical Applications
-
Law and Technology Centre
-
Long Term Conditions
-
Magnetic Resonance
-
Mathematical Modelling
-
Medicines Management
-
Molecular and Precision Biosciences
-
Multiwavelength Accretion and Astronomical Transients
-
National Biofilms Innovation Centre (NBIC)
-
National Centre for Research Methods
-
National Infrastructure Laboratory
-
Nature-Based Ocean Solutions
-
Nonlinear Semiconductor Photonics
-
Ocean Perception Group
-
Operational Research
-
Optical Engineering and Quantum Photonics Group
-
Paediatrics and Child Health - Clinical and Experimental Sciences
-
People, Property, Community
-
Photonic Systems, Circuits and Sensors Group
-
Physical Optics
-
Primary Care Research Centre
-
Quantum, Light and Matter Group
-
Silica Fibre Fabrication
-
Silicon Photonics
-
Skin Sensing Research Group
-
Southampton Ethics Centre
-
Southampton Health Technology Assessments Centre (SHTAC)
-
Southampton High Energy Physics group
-
Southampton Imaging
-
Southampton Theory Astrophysics and Gravity (STAG) Research Centre
-
Stefan Cross Centre for Women, Equality and Law
-
String theory and holography
-
The India Centre for Inclusive Growth and Sustainable Development
-
The Parkes Institute
-
Tony Davies High Voltage Laboratory
-
Ultrafast X-ray Group
-
Vision Science
-
WSA Exchange
-
Work Futures Research Centre (WFRC)
-
Support for researchers
-
Faculties, schools and departments
-
Interdisciplinary research
-
Find people and expertise
-
Research Search | Research projects
-
Research jobs
-
Business
-
Global